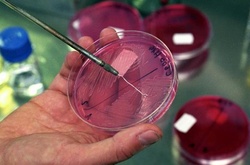
РФ знов лідирує: практично всі росіяни заражені паразитами

В Росії у боржників за комуналку відбирають дітей

Російські чиновники пояснили, що робиться це з добрих намірів: щоб не допустити замерзання дітей у будинках, в яких за борги відключили світло і тепло
У Росії з сімей боржників, які не сплатили за газ і електрику, розпорядилися вилучати дітей.
Про це йдеться в дорученні глави Зеленодольського району Татарстану Олександра Тигіна, оприлюдненому місцевою газетою «Вечірня Казань».
«Організувати роботу відділу опіки та піклування... по вилученню неповнолітніх дітей, які проживають у житлових приміщеннях із заборгованістю за енергоносії», - йдеться в документі.
Керівник прес-служби Зеленодольського райвиконкому Олександр Коршунов прокоментував рішення керівництва, пояснивши, що робиться це з добрих намірів: щоб не допустити замерзання дітей у будинках, в яких за борги відключили світло і тепло.

«За 2016 рік з таких сімей було вилучено 11 дітей на строк до трьох місяців. Всі ці діти тимчасово жили в притулку. Хіба правильно було б залишати дітей у будинках, в яких немає світла, тепла, де за ними немає належного догляду? Дітям у таких умовах жити неприпустимо», - сказав він.
Проблема з відключенням електрики і газу в оселях боржників за ЖКП, нагадує «Вечірня Казань», потрапила в поле зору керівників республіки рік тому, коли в селі Старий Кувак Леніногірського району згоріли у своїй хаті мати і п'ятеро дітей. Будинок був відключений від газопостачання, сім'я опалювала його електроприладами.

Коментарі — 0